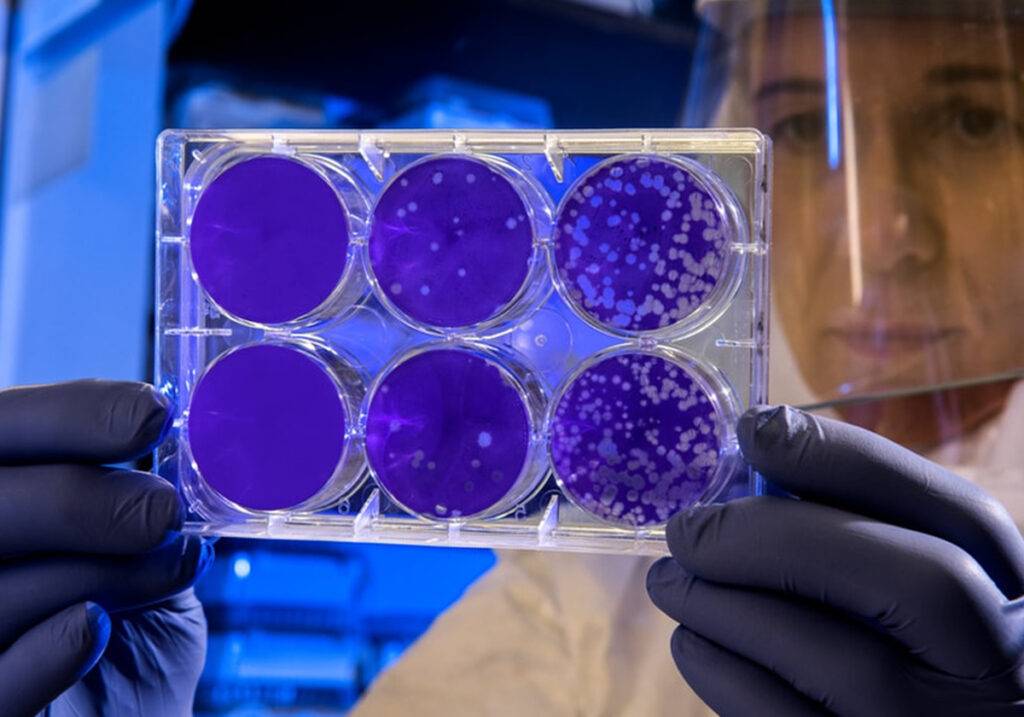

Эффективность бактерий для септиков и станций очистки
Многие владельцы загородных участков, дач и коттеджей считают, что бактерии, добавленные в септик или выгребную яму, позволяют перерабатывать сточные воды не хуже станций биологической очистки, но это очень большое заблуждение, ведь в станциях работу по очистке стоков выполняют не только бактерии, но и кислород. К тому же, конструкция таких станций предполагает многоэтапный процесс очистки, включающих в себя отстаивание, аэрацию, переливы и др.
Только станция очистки с помощью аэробных бактерий может обеспечить переработку канализационных стоков почти полностью – до 97%. Полученную очищенную воду можно без риска для окружающей среды использовать в хозяйстве – поливать грядки, заполнять ею пруд – или просто сливать в канаву. А заканчивающие свою жизнедеятельность бактерии после извлечения из станции и сушки становятся отличным удобрением.
В станциях также, как и в септике образуется осадок, но он настолько незначительный и скапливается в маленьком резервуаре, очистить который может любой собственник такой станции вручную.
Достоинства комбинированного способа очистки
Применение аэробных и анаэробных бактерий позволяет добиться наиболее эффективной очистки канализационных стоков. Отходы и вода, требующая очистки, при попадании в септик подвергаются действию двух видов бактерий.
Принцип действия:
- Первый этап: Анаэробные микроорганизмы разлагают большую часть твердых органических отходов;
- Второй этап: Биологические фильтры, в которых содержатся аэробные микробы, продолжают процесс очистки;
- Третий этап: Снова действуют бактерии гниения, которые преобразуют оставшиеся вещества в полезные удобрения и очищенную от большей части примесей воду.
Видео о том, как работает автономная канализация с бактериями
При добавлении же биологических препаратов всех этих неприятных последствий просто нет. Помимо этого, благодаря работе бактерий, реже возникает необходимость откачивать отходы, быстрее обеззараживают отходы, не разрушая при этом ни бетонные, ни пластиковые покрытия и стены, и не раздражая слизистые и кожные покровы человека. Эффективно применяется аэробная и анаэробная флора и при засорах в канализации, при необходимости быстрого начала очистительного процесса после долгого перерыва, при активном использовании канализационной системы, для очистки отстойника (септика) индивидуальной системы канализации и т.д.
Куда обратиться для сдачи мазка
Для сдачи мазка предлагаем обратиться в нашу клинику. Есть ряд неоспоримых плюсов в пользу выбора нашего медицинского центра:
- прием ведет врач-гинеколог высшей категории с большим опытом и заслуженной репутацией;
- обратиться можно в любой удобный день, так как работаем без праздников и выходных;
- есть возможность сдать мазок на дому, вызвав гинеколога по указанному адресу;
- имеется собственная лаборатория, оборудованная по требованиям современных стандартов;
- гарантия точного и быстрого результата;
- экономия вашего времени.
Клиника имеет свои филиалы, среди которых есть и тот, что расположен ближе к вам.
Записаться на прием можно лично, посетив клинику, либо позвонив по указанному на сайте телефону или отправив сообщение по предложенной на сайте форме (наш специалист обязательно свяжется с вами).
Различия бактериальных штаммов по типу применения в септиках
Различают аэробные бактерии и по типу применения в канализационной системе:
- способные успешно размножаться даже в неблагоприятных условиях, они нужны для первичного заселения дачных септиков;
- искусственно выведенные колонии бактерий, способные увеличивать уже имеющееся количество, их возможно успешно «подселять» к любым выпускаемым промышленностью штаммам микроорганизмов такого типа (если условие совместимости не соблюдается – септик перестанет работать со временем);
- бактерии, способные быстро размножаться и восстановить численность аэробов после воздействия на септическую среду щелочных или кислотных жидкостей (которые иногда попадают в септик во время уборки с моющими и чистящими средствами).
Перед тем как заселить в септическую емкость добавочных аэробных бактерий, необходимо провести техобслуживание устройства и лабораторно определить, какой именно вид микроорганизмов требуется в данный момент.
Сам принцип глубинной очистки сточных вод состоит в совместном применении разных видов очищения стоков. В канализационный бак всего лишь подселить штамм бактерий и установить струйный насос для подачи кислорода, то уровень очищения стоков будет невелик, поэтому очищать септики надо в несколько этапов.
Прежде всего стоки подвергают механической очистке и дроблению мусора на более мелкие фракции. После этого воды подаются по трубам в камеру с аэробными бактериями, которые формируют активный ил.
Инструкции по пользованию ↑
Для правильного применения того или иного вида бактерий необходимо внимательно ознакомиться с инструкцией.
Все производители в обязательном порядке указывают в ней следующие данные:
- состав. В него могут входить несколько видов микроорганизмов, каждый из которых отвечает за свой «фронт работы» — очистка, устранение запаха или жировых отложений и т.д;
- область применения – аэробные или анаэробные;
- дозировка, зависящая от объема септика;
- срок действия добавленного количества.
Причин добавления бактерий может быть две – появления неприятного запаха, недостаточная очистка. Процесс применения достаточно прост – нужно в камеру септика добавить состав.
При этом его действие начнется не моментально. Производители защищают бактерии внешней оболочкой, которая растворяется в жидкой среде. Только после этого они начнут действовать.
 Фото: Юнилос Астра
Фото: Юнилос Астра
Немаловажным является учет специфики конструкции. Например — септик Юнилос Астра отличается дозировкой от других аналогичных устройств.
Бактерии против органического мусора
Традиционная, но не очень известная сфера применения бактерий (точнее, микроорганизмов) — очистка окружающей среды: сточных вод, мусорных свалок, переработка органических отходов.
Жизнедеятельность бактерий обеспечивает биотопливо (это одно из развивающихся направлений «зеленой энергетики») — то есть любое топливо, которое получают из биомассы растительного, водорослевого материала или отходов животного происхождения. В результате получается этанол, метан, дизель. Микробы «превращают» органические отходы в форму, удобную для использования человеком. Самая удобная — «биогаз» на основе метана.
Сами по себе бактерии не могут решить проблему мусора в мире, только в триединстве с эконаправленными технологиями и усилиями всего общества. Необходимы раздельный сбор отходов, который обеспечит чистоту от тяжелых металлов (например, от батареек), и инфраструктура производства удобрения из органических отходов. Такие технологии будут массово применяться в будущем.
Думаю, что бактерия не может выйти из-под контроля, так как сама по себе она лишь биокатализатор в руках человека. Не автомат Калашникова убивает, а сами люди. Так и бактерии: применив бездумно тот или иной микроорганизм, можно навредить природе. При этом организм растет там, где есть для него условия. Не будет условий — не будет роста и выхода из-под контроля.
Микробиологические процессы широко применяют при переработке твердых коммунальных отходов (ТКО) с помощью компостирования и сбраживания. При компостировании обязательно присутствие кислорода, а при сбраживании, наоборот, нужно обеспечить его полное отсутствие.
Задача биотехнолога — создать благоприятные условия для жизнедеятельности микроорганизмов, которые преобразуют опасные и дурно пахнущие отходы в полезные продукты: компост, техногрунт, биогаз.
Рекомендуемые дозы
От объема септика зависит количество биологической добавки. Например, для одного кубического метра септика достаточно 250 грамм вещества. Можно купить отечественный препарат «Септи Трит». В его составе насчитывается 12 типов микроорганизмов. Препарат способен уничтожить до 80 процентов отходов в резервуаре. Запаха практически не остается. Уменьшается количество патогенных микробов.
Существует еще один очиститель для септиков, который называется «BIOFORCE Septic». На один кубический метр в септике необходимо 400 миллиграмм средства. Для поддержания активности препарата в септике необходимо каждый месяц добавлять по 100 грамм средства.
Биологический очиститель для септиков «Septic Comfort»продается в пакетиках по 12 грамм. На первые 4 дня необходимо загрузить 1 пакет. Этого количества достаточно на 4 кубических метра септика. Если септик имеет больший объем, то необходимо увеличить дозу до 2 пакетиков. Таким образом, на месяц используется 12 или 24 пакетика средства.
Противопоказания к сдаче мазка
Существенных противопоказаний к сдаче мазка не существует. Есть лишь рекомендации, которые, по возможности лучше соблюдать для более достоверных результатов теста:
- Во время месячных проводить такой анализ не желательно, потому что из-за кровянистых выделений врач не видит, где брать мазок.
- Другая причина заключается в том, что даже небольшое присутствие крови мешает проведению точного анализа.
- При обильных выделениях из влагалища, не связанных с месячными, также рекомендуется сначала устранить воспаление, а затем сдать мазок.
И все же каждый случай индивидуален. При некоторых состояниях мазок берется, несмотря на выделения любого характера. При сомнительном диагнозе следует сделать повторный анализ.
Вырабатывание энергии в тканях человека
 Некоторые ткани живых организмов обладают повышенной устойчивостью к пониженному содержанию кислорода. В стандартных условиях синтез аденозинтрифосфата идет аэробным путем, но при повышенных физических нагрузках и при воспалительных реакциях на первый план выходит анаэробный механизм.
Некоторые ткани живых организмов обладают повышенной устойчивостью к пониженному содержанию кислорода. В стандартных условиях синтез аденозинтрифосфата идет аэробным путем, но при повышенных физических нагрузках и при воспалительных реакциях на первый план выходит анаэробный механизм.
Аденозинтрифосфат (АТФ)
– это кислота, играющая важную роль при вырабатывании организмом энергии. Существует несколько вариантов синтеза этого вещества: один аэробный и целых три анаэробных.
К анаэробным механизмам синтеза АТФ относятся:
- перефосфорилирование между креатинфосфатом и АДФ;
- реакция трансфосфорилирования двух молекул АДФ;
- анаэробное расщепление глюкозы крови или запаса гликогена.
Особенности анаэробов для септика

В анаэробных септиках используются микроорганизмы, которые способны производить переработку стоков без доступа кислорода. Как правило, в отсеке, где находятся анаэробы, значительно ускоряются процессы гниения сточных вод. В результате этого процесса твёрдые соединения выпадают на дно в виде осадка. При этом жидкая составляющая стоков качественно очищается от различных органических включений.
Во время жизнедеятельности этих бактерий образуется большое количество твёрдых соединений. Все они оседают на дне локального очистного сооружения, поэтому оно нуждается в регулярной очистке. Если очистку производить не своевременно, то эффективная и слаженная работа очистной установки может быть полностью нарушена и выведена из строя.
Поскольку анаэробные представители бактерий в процесс своей жизнедеятельности вырабатывают метан, очистные сооружения, которые работают с использованием этих организмов, должны укомплектовываться эффективной системой вентиляции. В противном случае неприятный запах способен испортить окружающий воздух.
Анаэробный энергетический метаболизм
Все анаэробы – это типичные хемотрофы, поскольку в качестве источника энергии используют энергию химических связей. При этом энергетическими донорами могут быть как органические вещества (хемоорганотрофия), так и неорганические (хемолитотрофия).
У бактерий-анаэробов существуют две разновидности бескислородного метаболизма: дыхание и брожение. Принципиальное различие между ними заключается в механизме ассимиляции энергии.
Так, при брожении энергия сначала запасается в фосфагенной форме (например, в виде фосфоенолпирувата), а затем при участии цитозольных дегидрогеназ происходит субстратное фосфолирирование АДФ. Электроны при этом передаются эндогенному или экзогенному акцептору, который становится побочным продуктом процесса.

При дыхательном типе метаболизма энергия запасается в специфическом соединении – Pmf, который либо сразу используется для клеточных процессов, либо поступает в сосредоточенную на мембране электротранспортную цепь, где синтезируется АТФ. Только, в отличие от аэробного дыхания, конечным акцептором электронов служит не кислород, а другое соединение, которое может иметь как органическую, так и неорганическую природу.

Какой врач берет мазок из влагалища
Мазок из влагалища берет врач-гинеколог. Гинеколог – это узкий специалист, который диагностирует и лечит органы репродуктивной системы. В его компетенции взять также на анализ биоматериал из влагалища.
Происходит это во время осмотра на гинекологическом кресле. Женщина практически ничего не чувствует, забор материала на исследование из влагалища производится быстро, в течение нескольких минут.
От компетенции гинеколога зависит, насколько грамотно взяты мазки. А это влияет, в свою очередь, на результаты анализа.
Взять мазок – не самое сложное, нужны также грамотные лаборанты и хорошая лаборатория, а также умение правильно расшифровать данные. Иначе нарушаются степени чистоты мазка, результаты получаются не достоверными, искаженными.
В нашей клинике работает опытная команда гинекологов и лаборантов.
Часто встречающиеся симптомы и манипуляции в гинекологии:
- Выделения из влагалища
- Выделения из уретры
- Выделения из матки
- Внутриматочная спираль
- Женское бесплодие
- Задержка месячных
- Зуд во влагалище
- Коричневые выделения
- Прерывание беременности
- Боль в промежности
- Эрозия шейки матки
- Абортивные таблетки
- Вакуумный аборт
- Медикаментозный аборт
- Хирургический аборт
- Биопсия шейки матки
- Диагностическое выскабливание
- Фолликулометрия
- Записаться на прием к гинекологу
Бактерии против пластика
В 2016 году японские ученые опубликовали очень важное открытие. Собрав образцы почвы, воды и ила у завода по переработке бутылок в Осаке, они обнаружили бактерии, которые научились разлагать пластик
Бактерии Ideonella sakaiensis могли питаться только определенным видом пластика — ПЭТ, из которого делают бутылки и другую тару. Подобные открытия были сделаны в США и Германии.
Источник
Источник
Сейчас ученые работают над улучшением показателей этого фермента, что позволит в будущем построить объекты промышленного масштаба, где бактерии будут «переваривать» целые груды пластика. Такие бактерии необходимо подвергнуть биоинженерному изменению, чтобы они могли разлагать пластик в сотни или тысячи раз быстрее.
Какие заболевания относятся к половым инфекциям
Современная медицина насчитывает более 30 заболеваний, вызванных половыми инфекциями. Причем, к «знакомым» болезням все время добавляются новые.
Исконно древними являются:
- сифилис;
- гонорея;
- мягкий шанкр;
- хламидиоз;
- трихомониаз.
Среди относительно новых, которые вошли в список инфекций, передающихся половым путем:
- вирус папилломы человека – заболевание, которое в большинстве процентов приводит к онкологическому воспалению;
- вирус иммунодефицита человека – патология, разрушающая иммунитет человека и приводящая к болезни СПИД;
- донованоз – хроническая болезнь с язвенным поражением кожных покровов в области гениталий;
- герпес второго типа – вирусная патология, выражающаяся образованием мелких высыпаний в области гениталий и промежности и сопровождающаяся болью и зудом;
- гепатиты В и С – вирусное заболевание, поражающее внутренние органы организма, в том числе печень;
- лобковая вошь – паразит мелкого размера, который чаще поселяется на лобке;
- чесотка – паразитарное заболевание, передающееся как половым, так и контактным путем и поражающая кожные покровы;
- уреаплазмоз – заболевание, вызывающее жжение и боль, генитальные выделения, способное перейти к ребенку при рождение от больной матери;
- микоплазмоз – чаще хроническая патология, поражающая мочеполовую систему, и другие.
Так как многие инфекции долгое время не дают о себе знать, распознают их, подчас, поздно. За это время человек может передать их своему половому партнеру или даже нескольким лицам. Вирус также успевает во время скрытого периода значительно подорвать здоровье. Вот почему регулярно требуется проходить профилактический осмотр и сдавать кровь и мазок на скрытые инфекции.
Что вызывает флегмону, причины
Причиной развития флегмоны является проникновение, активное развитие и распространение инфекции. В результате чего формируется гнойное расплавление тканей (жировой, мышечной, и т.д.) с повреждением близлежащих органов (стенки сосуда, кишки, почки и т.д.).Флегмона обычно вызывается бактериями: чаще аэробными, такими как стрептококки, золотистый стафилококк и т.д, реже анаэробами (образующими споры).
Другие факторы, которые влияют на развитие флегмоны:
- наличие хронической интоксикации за счет хронического воспаления, отравления, приема химиопрепаратов, лучевой болезни,
- обширные тяжелые травмы,
- состояние иммунитета пациента,
- вирулентность бактерий (способность вызвать заболевание).
Бактерии могут проникнуть через царапину, укус насекомого или травму с образованием флегмоны прямо под кожей. Также могут перемещаться с током крови из воспаленного органа (абсцесс почки, легкого, печени, аппендикулярный абсцесс, параректальный абсцесс и т.д.).
Бактерии могут также прикрепляться к стенке внутреннего органа, такого как стенка желудка или аппендикс, и образовывать флегмону.
Люди с ослабленной иммунной системой могут быть особенно уязвимы для формирования флегмоны.
Симптомы и проявления флегмоны
Различаются в зависимости от места и тяжести инфекции.Основными симптомами являются покраснение кожи и отек в месте воспаления.
 Флегмона мягких тканей на фоне прогрессирующего абсцесса
Флегмона мягких тканей на фоне прогрессирующего абсцесса
Пораженная часть тела чувствительна к прикосновениям и болит. К этому симптому позже добавляется лихорадка. Могут возникать опухшие связанные лимфатические узлы.
Проявления флегмоны кожи
- покраснение кожи
- воспаление
- блезненный отек тканей
- опухшие лимфатические узлы
- повышенная локальная температура
- усталость
- лихорадка
- головная боль
Внутренние органы
Флегмона может поражать любой внутренний орган. Симптомы могут варьироваться в зависимости от органа и конкретных бактерий.
- нарушение функции органа
- боль в животе
- лихорадка
- озноб
- тошнота
- рвота
- понос
- кишечная непроходимость
- повышенная температура тела
- потеря аппетита
- увеличение жажды
- потоотделение
- увеличение лейкоцитов (лейкоцитоз)
Понятие анаэробных бактерий и их классификации
Термин «анаэробы» появился в 1861 году, благодаря работам Луи Пастера.
Анаэробные бактерии – это микроорганизмы, которые развиваются вне зависимости от присутствия в питательной среде кислорода. Они получают энергию путем субстратного фосфорилирования
. Различают факультативные и облигатные аэробы, а также другие виды.

Наиболее значимые анаэробы – бактероиды
Наиболее значимыми аэробами являются бактероиды. Примерно пятьдесят процентов всех гнойно-воспалительных процессов
, возбудителями которых могут быть анаэробные бактерии, приходится на бактероиды.
Бактероиды – это род граммотрицательных облигатных анаэробных бактерий. Это палочки с биполярной окрашиваемостью, размер которых не превышает 0,5-1,5 на 15 мкм. Вырабатывают токсины и ферменты, которые могут вызывать вирулентность. Различные бактероиды обладают разной устойчивостью к антибиотикам: встречаются как устойчивые, так и чувствительные к антибиотикам.
Уход за водоемами

Еще одним вариантом использования анаэробных или аэробных микробов является очистка водоемов, в частности садовых прудов. В отличие от больших естественных водоемов, где биологическое равновесие может восстанавливаться само собой, небольшие пруды на садовых участках требуют тщательного ухода. Переизбыток органических веществ в воде быстро приводит к ее помутнению и затхлости. И того, и другого можно избежать, если добавить в пруд препарат с микроорганизмами.
В результате, сначала специальный реагент собирает загрязняющие вещества хлопьями, которые оседают на дно. А здесь за них уже принимаются бактерии, содержащиеся все в том же препарате, которые разлагают органику. При этом на зиму бактерии-чистильщики «уходят в спячку», а весной вновь начинают свою работу.
Все эти препараты абсолютно безвредны для человека и всех обитателей пруда. Главное, о чем необходимо помнить, что наиболее эффективно микроорганизмы будут работать только в закрытых водоемах (нет поступлений и выхода воды).
Виды
Достижение желаемого быстрого и главное результативного эффекта от применения биопрепаратов практически полностью зависит от того насколько правильно подобраны бактерии для применения.
Основными критериями выбора препаратов для применения должны быть:
- Конструкция септика.
- Производительность системы.
- Технические характеристики системы.
- Местные условия установки очистных сооружений и погодные условия.
И соответственно, какие именно биологически активные виды бактерий будут использованы:
- анаэробные;
- аэробные;
- препараты комплексного или комбинированного способа очистки;
Анаэробные бактерии

Биопрепараты такого типа основаны на биологических свойствах бактерий, жизнедеятельность которых происходит без доступа кислорода. По сути, такие средства отлично работают в замкнутых пространствах септиков, где происходит первичная очистка стоков.
К положительным сторонам препаратов нужно отнести:
- Легкость применения – дозу раствора достаточно смыть в унитаз дома, для того чтобы он попал в септик.
- Быстроту начала работы средства – работа начинается буквально сразу – эффект начинает давать результаты через 6-8 часов.
- При правильном приготовлении и введении раствора, добавление следующих доз требуется не ранее, чем через 14-21 суток.
К недостаткам такого вида средств относится:
- Довольно жесткий температурный режим применения.
- Необходимость периодического добавления раствора в сточные воды для увеличения концентрации бактерий.
- Для эффективной работы необходимо ограничить или вообще исключить определенные виды моющих средств, стиральных порошков, отбеливателей, в особенности содержащих хлор.
Ну и конечно же:
- Выпадение твердого осадка, быстрое заиливание емкости танка.
- Токсичность выпавшего донного садка, ввиду наличия вредных микроорганизмов.
- Специфический запах метана, образуемого в отложениях.
Аэробные

Средства очистки основными элементами, которых являются аэробные бактерии, отличаются тем, что способны проводить разложение механических включений и растворимых веществ в среде насыщенной кислородом. Проще говоря, основным условием работы такого препарата является наличие кислорода в камере очистки.
Аэробные препараты, кроме этого, требуют применения и более высокой технологии переработки отходов – септик доочистки желательно оборудовать компрессором для нагнетания воздуха и смешивания его со стоками для образования мелких пузырьков воздуха.
К положительным сторонам таких препаратов относятся:
- Высокая степень очистки стоков (имеется в виду доочистки, после применения анаэробных средств).
- Практическое отсутствие донных отложений в септике.
- Возможность применения в составе биофильтра или на полях фильтрации.
- Очищенные стоки аэробными препаратами могут быть выведены в грунт без дополнительной обработки.
К недостаткам следует отнести:
- Дороговизну применения технологии в чистом ее виде – с использованием нагнетающего компрессора, текстильных полей для колоний бактерий.
- Наличие определенной температуры для продуктивного распространения организмов;
Комбинированный способ очистки
Комбинированный способ, или по-другому универсальный, позволяет использовать препараты, содержащие оба вида живых организмов. При этом, качество такой очистки стоков вполне приемлемо и позволяет использовать средство как в септиках закрытого типа, так и открытого.
К удобствам таких средств нужно отнести:
- Простоту применения.
- Достаточно хороший результат очистки.
- Возможность употребления для различных условий и конструкций местной канализационной системы.
Но и как и препараты остальных групп, комбинированные комплексы сочетают в себе недостатки обеих видов как анаэробных, так и аэробных видов.
Схема работы септика на аэробных бактериях
Для систем глубокой биологической очистки применяются анаэробные бактерии. В септик по средствам компрессора подается воздух, который вступает в реакцию с имеющимися стоками. В воздухе есть кислород. Благодаря ему аэробные бактерии начинают очень быстро размножаться.
Аэробные септики имеют ряд преимуществ:
- Вода очищается с высокой степенью и не требует дальнейшей обработки.
- Осадок, который остается на дне резервуара (ил) можно использовать в качестве удобрения на огороде или в саду.
- Образуется небольшое количество ила.
- При реакции не выделяется метан, соответственно нет неприятного запаха.
- Септик часто очищается, что позволяет не собираться большому количеству ила.
Виды половых инфекций
Инфекционные заболевания, передающиеся через сексуальные контакты, подразделяют на пять основных видов:
- Бактериальные: паховая гранулема, мягкий шанкр, сифилис, лимфогранулема, хламидиоз, гонорея, микоплазмоз, уреаплазмоз.
- Вирусные: ВИЧ, вирус простого герпеса второго типа, остроконечные кондиломы, папилломавирус, гепатит В, цитомегаловирус, контагиозный моллюск, саркома Капоши, вирус Зика.
- Прозойные: трихомониаз.
- Паразитарные: лобковый педикулез, чесотка.
- Грибковая инфекция: кандидоз или молочница.
Впрочем, грибки Кандида входят в состав условно-патогенной флоры влагалища. Но если их количество многократно увеличивается, возникают все симптомы заболевания. Увеличение грибков происходит на фоне общего снижения иммунитета, не редко в совокупности с другими венерическими инфекциями.
Какое обследование необходимо при половых инфекциях
Все половые инфекции в первую очередь требуют анализа выделений из мочеиспускательного канала и из влагалища. Этот биоматериал берется при первом посещении гинеколога, венеролога или уролога.
Далее необходимо сдать:
- общий анализ крови;
- общий анализ мочи;
- кровь на антитела;
- ПЦР-диагностика на срытые инфекции;
- соскоб с эпителия при паразитарном поражении;
- при необходимости – биопсия.
При подозрении на анальный путь передачи инфекции, проводится забор материала из кишки на бактериологическое исследование, забор крови из вены, аноскопия и проктоскопия. Назначается консультация проктолога.
Часто встречающиеся венерические болезни и симптомы:
- Выделения из половых путей
- Уреаплазмоз
- Микоплазмоз
- Хламидиоз
- Гонорея
- Гарднереллез
- Выделения у женщин
- Выделения у мужчин
- Зуд во влагалище
- Баланопостит
- Боль в мошонке
- Боль при мочеиспускании
- Выделения из уретры
- Воспаление простаты
- Отек уретры
- Кровь в сперме
- Зуд вульвы
- Гной на половых губах
- Жжение в уретре
- Боль в промежности
- Покраснение головки полового члена
- Учащенное мочеиспускание
- Зуд головки полового члена
- Зуд мошонки
- Выпадения прямой кишки
- Разрыв крайней плоти
Польза от анаэробных микробов для организма
Однако не нужно думать, что все бактерии, находящиеся в нашем теле – безусловное зло, приводящее к болезням. В последние годы происходит переоценка роли микроорганизмов для нашего здоровья и качества нашей жизни. Живущие в внутри нас и на поверхности тела бактерии – не просто случайные попутчики, а наши партнеры, вместе с которыми мы рука об руку прошли миллионы лет эволюции.
Они делают для нас работу, которую не можем сделать мы сами. Например, большая часть витаминов и нейромедиаторов, необходимых для жизни, вырабатывается бактериями, живущими у нас в кишечнике. А значит, от их процветания зависит и наше благополучие, и забота о здоровье должна распространяться и на микрофлору. Желательно не злоупотреблять без необходимости антибиотиками, чтобы не разрушать ее баланс, а также есть больше клетчатки, которой питаются бактерии, и периодически пить пробиотики.
Классификация анаэробов
По отношению к кислороду выделяют две группы анаэробных бактерий:
- факультативные – могут получать энергию как с участием кислорода, так и без него, переход с одного типа метаболизма на другой зависит от условий среды;
- облигатные – никогда не используют O2.
Для факультативных анаэробов бескислородный тип метаболизма имеет приспособительное значение, и бактерии прибегают к нему только в крайнем случае, при попадании в анаэробную среду. Это объясняется тем, что кислородное дыхание энергетически гораздо выгодней.
У другой группы анаэробов отсутствует биохимический механизм использования O2 для окисления соединений, и присутствие этого элемента в окружающей среде не только не полезно, но и токсично.
Выделяют несколько типов облигатных анаэробов, различающихся по устойчивости к присутствию молекулярного кислорода:
- строгие погибают даже при незначительной концентрации O2;
- умеренно строгие характеризуются средней или высокой устойчивостью к присутствию кислорода;
- аэротолерантные – особая группа прокариот, способная не только выживать, но и расти в воздушной среде.
Отношение конкретной бактерии к кислороду можно определить по характеру ее роста в толще питательной среды.

К аэротолерантным микроорганизмам относят молочнокислые бактерии. Некоторые виды (например, Clostridium) могут быть устойчивы к высокой концентрации кислорода за счет образования эндоспор.

Польза от анаэробных микробов в хозяйстве
Другая выгода, которую могут принести полезные микроорганизмы, – быстрая переработка сточных вод. Существуют специальные бактерии (как анаэробные, так и аэробные), которые добавляют в сточные сооружения, чтобы они ускорили очистку. В каком-то смысле они являются пробиотиками для канализации. Анаэробные бактерии для септика используют бескислородное брожение и способны ускорить процесс гниения сточных вод без необходимости закачивать в стоки воздух. Недостатком этого метода очистки является выпадение большого количества твердого осадка, который нужно регулярно очищать, а также возникновение неприятного запаха, проявляющегося из-за того, что данные организмы выделяют газ метан.
Чтобы не было проблем с канализацией

Незаменимую помощь могут оказать аэробные или анаэробные бактерии на дачных участках и загородных домах без центральной канализации. Добавленные в выгребную яму бактерии уже через несколько дней полностью устраняют неприятный запах. Исчезнут и насекомые – постоянные спутники уличных туалетов. Кроме того, само содержимое ямы значительно уменьшится в объеме и превратиться из проблемы в пользу – станет удобрением.
Раньше для устранения запаха некоторые использовали хлорную известь (хлорку). Однако эффект от ее применения был довольно сомнительным. Вместо одного запаха на участке появлялся другой, не менее неприятный – резкий, въедливый запах хлорки.
Кроме того, после использования этого препарата долгое время ничего на месте туалета и рядом с ним не растет, даже сорные травы. Да и естественный процесс разложения отходов жизнедеятельности значительно замедлялся или даже вовсе прекращался.
Культивирование анаэробных микробов
Для диагностики таких инфекций необходим посев на анаэробные бактерии, который позволит сказать, какие именно возбудители спровоцировали заболевание. Однако исследование данных микроорганизмов осложняется тем фактом, что соприкосновение с кислородом может их уничтожить и сделать результат анализа не показательным
Поэтому при выделении анаэробных бактерий большое внимание уделяется созданию бескислородных условий при хранении и исследовании образцов, для чего используют различные приемы. Например, их можно культивировать в вакуумном аппарате, где вместо воздуха – газовая смесь
Или использовать химические вещества, поглощающие кислород. Из-за того, что анаэробные бактерии сложно вырастить, и результатов нужно какое-то время ждать, чаще всего лечение начинается еще до получения их ответов. Терапия подобных инфекций обычно предполагает хирургическое удаление гнойного очага и антибактериальные процедуры.
Анаэробное деструктивное сообщество бактерий
Данный тип микробиоты образуется в богатых органикой экологических нишах, в которых кислород практически полностью израсходован (затапливаемые почвы, подземные гидросистемы, илистые отложения и т.д.). Здесь происходит ступенчатая деградация органических соединений, осуществляемая двумя группами бактерий:
- первичные анаэробы отвечают за первый этап дессимиляции органики;
- вторичные анаэробы – это микроорганизмы с метаболизмом дыхательного типа.
Среди первичных анаэробов различают гидролитиков и диссипотрофов, которые связаны друг с другом трофическими взаимодействиями. Гидролитики образуют биопленки на поверхности твердых субстратов и продуцируют гидролитические экзоферменты, которые расщепляют сложные органические соединения на олигомеры и мономеры.
Образовавшиеся питательный субстрат в первую очередь используются самими гидролитиками, но также и диссипотрофами. Последние обычно менее кооперированы и не выделяют значительных количеств экзоферментов, поглощая готовые продукты гидролиза биополимеров. Характерным представителем диссипотрофов являются бактерии рода Syntrophomonas.






































